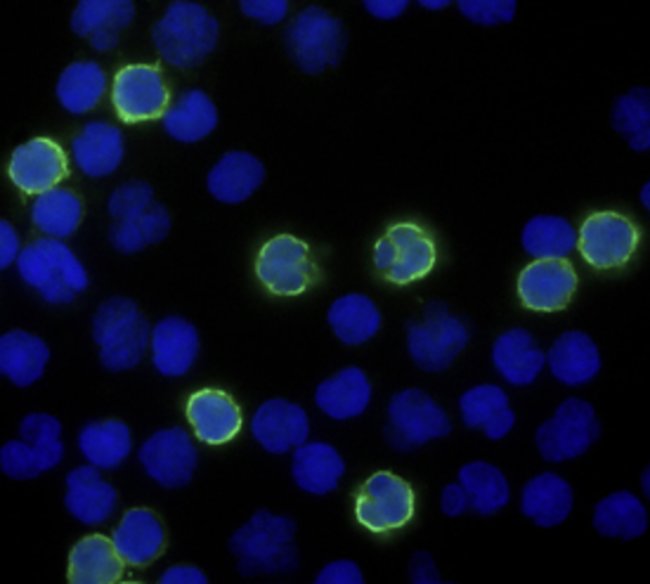

Anti-Cd8, Alexa Fluor 488, Clone: 37006, Mouse Monoclonal Antibody, Each
$ 478.93
|
|
Details:
CD8 Monoclonal specifically detects CD8 in Human samples. It is validated for Flow Cytometry, Immunocytochemistry.
Additional Information
| SKU | 10139350 |
|---|---|
| UOM | Each |
| UNSPSC | 12352203 |
| Manufacturer Part Number | FAB1509G100 |
